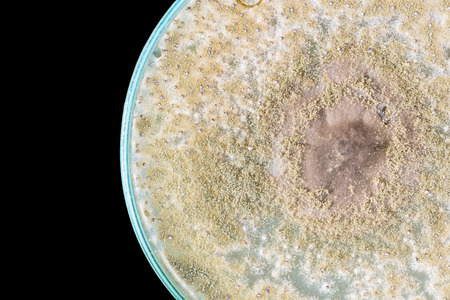
macro of fungi on petri dish isolated on black backgroundの写真素材

写真素材 - macro of fungi on petri dish isolated on black background
作品情報
macro of fungi on petri dish isolated on black background
- ID:43226025
- 作品種別:写真
- 作者名:kwanchaichaiudom
キーワード
- agar
- antibiotics
- background
- bacteria
- bacterium
- biology
- biotechnology
- black background
- close
- colonies
- culture
- disease
- dish
- experiment
- fungi
- genetics
- growth
- health
- hygiene
- isolated
- lab
- laboratory
- macro
- medical
- medicine
- microbiology
- microorganisms
- penicillin
- petri
- plate
- research
- science
- scientific
- sickness
- study
- up
類似作品
Hypholoma capno...
Nature Brown mu...
Mushroom growin...
Bracket fungus ...
Mushroom wetwoo...
Amanita muscari...
Mushroom
Bracket fungus ...
Winter mushroom...
Dive into the v...
Close-up of mus...
A detailed clos...
Orange mushroom...
Brown mushroom ...
Mushroom forest...
close-up of mag...
Vibrant orange ...
Gyromitra gigas...
Beautiful fores...
Wild mushrooms,...
Vibrant orange ...
Mushrooms growi...
mashroom forest...
Amanita and col...
Wild mushrooms,...
Mushroom is gro...
Wild mushrooms,...
Cookeina sulcip...
Raw champignons...
Mushroom growin...
Ganoderma Lucid...
Closeup of Imma...
poisonous paras...
Champagne mushr...
Macro of a grou...
Inedible mushro...
mushroom farm
Mushroom in the...
Auricularia aur...
pink mushroom c...
A bug's eye vie...
Mushroom
A stunning clos...
Group of amazin...
Hairy Stereum (...
Wild mushrooms,...
Trametes versic...
Mysterious mush...
fungi that grow...